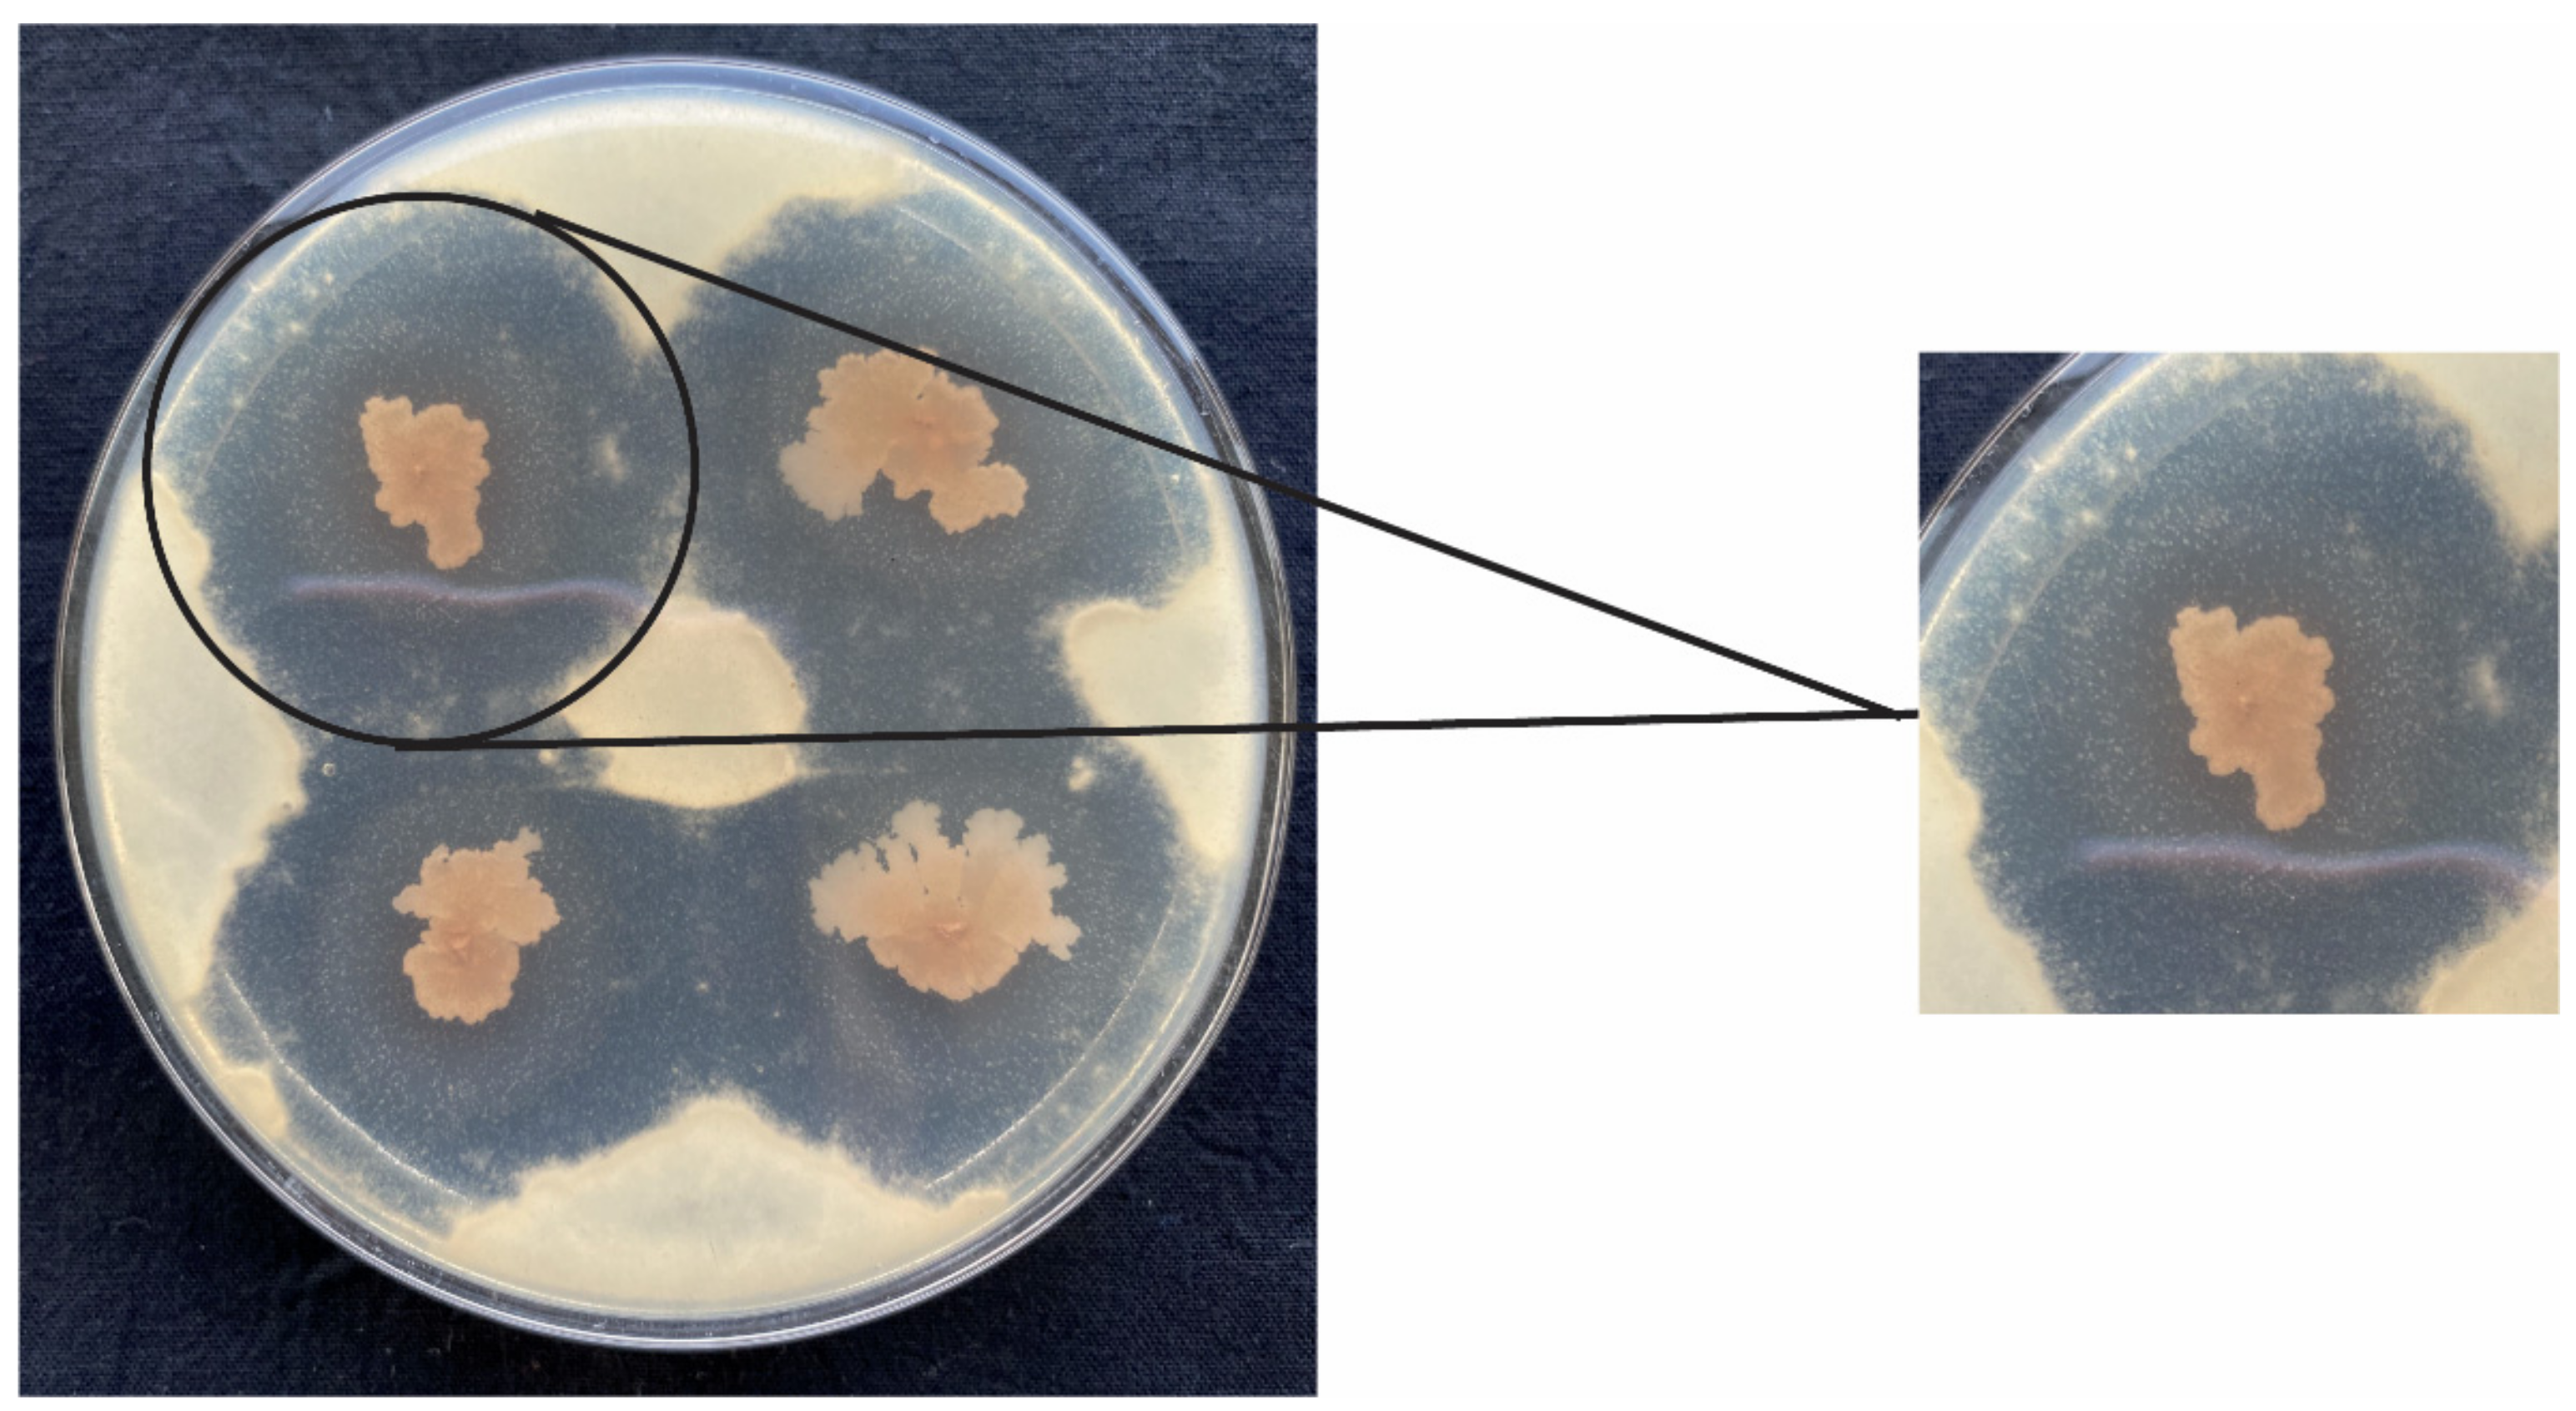
Jof 08 00080 g002 550

Developing Penicillium digitatum Management Strategies on Post-Harvest Citrus Fruits with Metabolic Components and Colonization of Bacillus subtilis L1-21
Abstract
:1. Introduction
2. Materials and Methods
2.1. Bacterial Strains and Culture Conditions
2.2. Fruit Materials
2.3. Isolation and Identification of Potential Penicillium Isolates
2.4. Cross-Talk Experiment between Fungal Pathogen and Potential Endophyte
2.5. Biocontrol Efficacy Assay
2.6. Identification of Bacillus Subtilis L1-21 Extracts Using GC-MS
2.7. Screening Medium for Producing Antifungal Substances
2.8. Antifungal Stability of Bacillus Subtilis L1-21 Culture Filtrate
2.9. Characterization of the Antifungal Compounds Using LC-MS
2.10. Colonization of GFP-Tagged Endophytic Strain
2.11. Data Analysis
3. Results
3.1. Morphological and Molecular Identification
3.2. In Vitro Biocontrol Efficacy and Effects of Bacillus Subtilis L1-21 on Penicillium Digitatum
3.3. Extraction of Antifungal Compounds of Bacillus Subtilis L1-21 Using GC-MS
3.4. Culture Filtrate of Endophyte Bacillus Subtilis L1-21 on Spore Germination
3.5. Stability of Bacillus Subtilis L1-21 Culture Filtrate under Different Conditions
3.6. Characterization of Antifungal Compounds from Endophyte Bacillus Subtilis L1-21 Using LC-MS
3.7. The Colonization Ability of Bacillus Subtilis L1-21
4. Discussion
5. Conclusions
Supplementary Materials
Author Contributions
Funding
Institutional Review Board Statement
Informed Consent Statement
Data Availability Statement
Conflicts of Interest
References
- Wu, G.A.; Terol, J.; Ibanez, V.; López-García, A.; Pérez-Román, E.; Borredá, C.; Domingo, C.; Tadeo, F.R.; Carbonell-Caballero, J.; Alonso, R.; et al. Genomics of the origin and evolution of Citrus. Nature 2018, 554, 311–316. [Google Scholar] [CrossRef] [Green Version]
- Spreen, T.H.; Gao, Z.; Fernandes, W.; Zansler, M.L. Chapter 23—Global economics and marketing of citrus products. In The Genus Citrus; Talon, M., Caruso, M., Gmitter, F.G., Eds.; Woodhead Publishing: Sawston, UK, 2020; pp. 471–493. [Google Scholar]
- Wang, S.; Ruan, C.; Yi, L.; Deng, L.; Yao, S.; Zeng, K. Biocontrol ability and action mechanism of Metschnikowia citriensis against Geotrichum citri-aurantii causing sour rot of postharvest citrus fruit. Food Microbiol. 2020, 87, 103375. [Google Scholar] [CrossRef]
- Lucon, C.M.M.; Guzzo, S.D.; de Jesus, C.O.; Pascholati, S.F.; de Goes, A. Postharvest harpin or Bacillus thuringiensis treatments suppress citrus black spot in ‘Valencia’ oranges. Crop Prot. 2010, 29, 766–772. [Google Scholar] [CrossRef]
- Costa, J.H.; Bazioli, J.M.; de Moraes Pontes, J.G.; Fill, T.P. Penicillium digitatum infection mechanisms in citrus: What do we know so far? Fungal Biol. 2019, 123, 584–593. [Google Scholar] [CrossRef] [PubMed]
- Marcet-Houben, M.; Ballester, A.R.; de la Fuente, B.; Harries, E.; Marcos, J.F.; González-Candelas, L.; Gabaldón, T. Genome sequence of the necrotrophic fungus Penicillium digitatum, the main postharvest pathogen of citrus. BMC Genom. 2012, 13, 646. [Google Scholar] [CrossRef] [PubMed] [Green Version]
- Elsherbiny, E.A.; Dawood, D.H.; Safwat, N.A. Antifungal action and induction of resistance by β-aminobutyric acid against Penicillium digitatum to control green mold in orange fruit. Pestic. Biochem. Physiol. 2021, 171, 104721. [Google Scholar] [CrossRef] [PubMed]
- Njombolwana, N.S.; Erasmus, A.; Fourie, P.H. Evaluation of curative and protective control of Penicillium digitatum following imazalil application in wax coating. Postharvest Biol. Technol. 2013, 77, 102–110. [Google Scholar] [CrossRef]
- Chen, C.; Wan, C.; Peng, X.; Chen, J. A flavonone pinocembroside inhibits Penicillium italicum growth and blue mold development in ‘Newhall’ navel oranges by targeting membrane damage mechanism. Pestic. Biochem. Physiol. 2020, 165, 104505. [Google Scholar] [CrossRef]
- Talibi, I.; Boubaker, H.; Boudyach, E.H.; Ait Ben Aoumar, A. Alternative methods for the control of postharvest citrus diseases. J. Appl. Microbiol. 2014, 117, 1–17. [Google Scholar] [CrossRef]
- Cui, W.; He, P.; Munir, S.; He, P.; Li, X.; Li, Y.; Wu, J.; Wu, Y.; Yang, L.; He, Y. Efficacy of plant growth promoting bacteria Bacillus amyloliquefaciens B9601-Y2 for biocontrol of southern corn leaf blight. Biol. Control 2019, 139, 104080. [Google Scholar] [CrossRef]
- Munir, S.; Ahmed, A.; Li, Y.; He, P.; Singh, B.K.; He, P.; Li, X.; Asad, S.; Wu, Y.; He, Y. The hidden treasures of citrus: Finding Huanglongbing cure where it was lost. Crit. Rev. Biotechnol. 2021, 2021, 1–16. [Google Scholar] [CrossRef] [PubMed]
- Bu, S.; Munir, S.; He, P.; Li, Y.; Wu, Y.; Li, X.; Kong, B.; He, P.; He, Y. Bacillus subtilis L1-21 as a biocontrol agent for postharvest gray mold of tomato caused by Botrytis cinerea. Biol. Control 2021, 157, 104568. [Google Scholar] [CrossRef]
- Munir, S.; Li, Y.; He, P.; He, P.; Ahmed, A.; Wu, Y.; He, Y. Unraveling the metabolite signature of citrus showing defense response towards Candidatus Liberibacter asiaticus after application of endophyte Bacillus subtilis L1-21. Microbiol. Res. 2020, 234, 126425. [Google Scholar] [CrossRef] [PubMed]
- Jiao, R.; Munir, S.; He, P.; Yang, H.; Wu, Y.; Wang, J.; He, P.; Cai, Y.; Wang, G.; He, Y. Biocontrol potential of the endophytic Bacillus amyloliquefaciens YN201732 against tobacco powdery mildew and its growth promotion. Biol. Control 2020, 143, 104160. [Google Scholar] [CrossRef]
- Arrebola, E.; Sivakumar, D.; Korsten, L. Effect of volatile compounds produced by Bacillus strains on postharvest decay in citrus. Biol. Control 2010, 53, 122–128. [Google Scholar] [CrossRef]
- Cheffi, M.; Chenari Bouket, A.; Alenezi, F.N.; Luptakova, L.; Belka, M.; Vallat, A.; Rateb, M.E.; Tounsi, S.; Triki, M.A.; Belbahri, L. Olea europaea L. root endophyte Bacillus velezensis OEE1 counteracts oomycete and fungal harmful pathogens and harbours a large repertoire of secreted and volatile metabolites and beneficial functional genes. Microorganisms 2019, 7, 314. [Google Scholar] [CrossRef] [PubMed] [Green Version]
- Waewthongrak, W.; Pisuchpen, S.; Leelasuphakul, W. Effect of Bacillus subtilis and chitosan applications on green mold (Penicilium digitatum Sacc.) decay in citrus fruit. Postharvest Biol. Technol. 2015, 99, 44–49. [Google Scholar] [CrossRef]
- Leelasuphakul, W.; Hemmanee, P.; Chuenchitt, S. Growth inhibitory properties of Bacillus subtilis strains and their metabolites against the green mold pathogen (Penicillium digitatum Sacc.) of citrus fruit. Postharvest Biol. Technol. 2008, 48, 113–121. [Google Scholar] [CrossRef]
- Wang, Z.; Jiang, M.; Chen, K.; Wang, K.; Du, M.; Zalán, Z.; Hegyi, F.; Kan, J. Biocontrol of Penicillium digitatum on postharvest citrus fruits by Pseudomonas fluorescens. J. Food Qual. 2018, 2018, 2910481. [Google Scholar] [CrossRef] [Green Version]
- Lai, K.; Chen, S.; Hu, M.; Hu, Q.; Geng, P.; Weng, Q.; Jia, J. Control of postharvest green mold of citrus fruit by application of endophytic Paenibacillus polymyxa strain SG-6. Postharvest Biol. Technol. 2012, 69, 40–48. [Google Scholar] [CrossRef]
- Liu, X.; Wang, J.; Gou, P.; Mao, C.; Zhu, Z.-R.; Li, H. In vitro inhibition of postharvest pathogens of fruit and control of gray mold of strawberry and green mold of citrus by aureobasidin A. Int. J. Food Microbiol. 2007, 119, 223–229. [Google Scholar] [CrossRef] [PubMed]
- Tian, Z.; Chen, C.; Chen, K.; Liu, P.; Fan, Q.; Zhao, J.; Long, C.A. Biocontrol and the mechanisms of Bacillus sp. w176 against postharvest green mold in citrus. Postharvest Biol. Technol. 2020, 159, 111022. [Google Scholar] [CrossRef]
- Chen, K.; Tian, Z.; Luo, Y.; Cheng, Y.; Long, C.A. Antagonistic activity and the mechanism of Bacillus amyloliquefaciens DH-4 against citrus green mold. Phytopathology 2018, 108, 1253–1262. [Google Scholar] [CrossRef] [Green Version]
- Ahmed, A.; Munir, S.; He, P.; Li, Y.; He, P.; Yixin, W.; He, Y. Biocontrol arsenals of bacterial endophyte: An imminent triumph against clubroot disease. Microbiol. Res. 2020, 241, 126565. [Google Scholar] [CrossRef]
- Jiao, R.; Cai, Y.; He, P.; Munir, S.; Li, X.; Wu, Y.; Wang, J.; Xia, M.; He, P.; Wang, G.; et al. Bacillus amyloliquefaciens YN201732 produces lipopeptides with promising biocontrol activity against fungal pathogen Erysiphe cichoracearum. Front. Cell. Infect. Microbiol. 2021, 11, 999. [Google Scholar] [CrossRef] [PubMed]
- Chai, Y.; Winans, S.C. RepB protein of an Agrobacterium tumefaciens Ti plasmid binds to two adjacent sites between repA and repB for plasmid partitioning and autorepression. Mol. Microbiol. 2005, 58, 1114–1129. [Google Scholar] [CrossRef] [PubMed]
- Munir, S.; Li, Y.; He, P.; Huang, M.; He, P.; He, P.; Cui, W.; Wu, Y.; He, Y. Core endophyte communities of different citrus varieties from citrus growing regions in China. Sci. Rep. 2020, 10, 3648. [Google Scholar] [CrossRef] [Green Version]
- Yu, L.; Li, X.; Lan, H.J. Effect of bacteriostaticon Penicillium italicum in stored citruses by using the extracts of Ginkgo bilobaleaves. Food. Mach. 2010, 6, 60–62. [Google Scholar]
- Li, X.; Munir, S.; Xu, Y.; Wang, Y.; He, Y. Combined mass spectrometry-guided genome mining and virtual screening for acaricidal activity in secondary metabolites of Bacillus velezensis W1. R. Soc. Chem. 2021, 11, 25441–25449. [Google Scholar] [CrossRef]
- Zhang, J.; Wei, L.; Yang, J.; Ahmed, W.; Wang, Y.; Fu, L.; Ji, G. Probiotic consortia: Reshaping the rhizospheric microbiome and its role in suppressing root-rot disease of Panax notoginseng. Front. Microbiol. 2020, 11, 701. [Google Scholar] [CrossRef]
- Papoutsis, K.; Mathioudakis, M.M.; Hasperué, J.H.; Ziogas, V.J. Non-chemical treatments for preventing the postharvest fungal rotting of citrus caused by Penicillium digitatum (green mold) and Penicillium italicum (blue mold). Trends Food Sci. Technol. 2019, 86, 479–491. [Google Scholar] [CrossRef]
- De Andrade, C.J.; de Andrade, L.M.; Bution, M.L.; Dolder, M.A.H.; Barros, F.F.C.; Pastore, G.M. Optimizing alternative substrate for simultaneous production of surfactin and 2, 3-butanediol by Bacillus subtilis LB5a. Biocatal. Agric. Biotechnol. 2016, 6, 209–218. [Google Scholar] [CrossRef]
- Sun, D.; Liao, J.; Sun, L.; Wang, Y.; Liu, Y.; Deng, Q.; Zhang, N.; Xu, D.; Fang, Z.; Wang, W.J. Effect of media and fermentation conditions on surfactin and iturin homologues produced by Bacillus natto NT-6: LC–MS analysis. AMB Express 2019, 9, 120. [Google Scholar] [CrossRef]
- Fahim, S.; Dimitrov, K.; Gancel, F.; Vauchel, P.; Jacques, P.; Nikov, I. Impact of energy supply and oxygen transfer on selective lipopeptide production by Bacillus subtilis BBG21. Bioresour. Technol. 2012, 126, 1–6. [Google Scholar] [CrossRef]
- Pupin, M.; Flissi, A.; Jacques, P.; Leclère, V.J. Bioinformatics tools for the discovery of new lipopeptides with biocontrol applications. Eur. J. Plant Pathol. 2018, 152, 993–1001. [Google Scholar] [CrossRef]
- Li, L.; Xin, Z.; Okwong, R.O.; OuYang, Q.; Che, J.; Zhou, J.; Tao, N. Antofine inhibits postharvest green mold due to imazalil-resistant Penicillium digitatum strain Pdw03 by triggering oxidative burst. J. Fish Biol. 2021, 45, e13751. [Google Scholar] [CrossRef] [PubMed]
- Wu, L.; Wu, H.; Chen, L.; Xie, S.; Zang, H.; Borriss, R.; Gao, X. Bacilysin from Bacillus amyloliquefaciens FZB42 has specific bactericidal activity against harmful algal bloom species. Appl. Environ. Microbiol. 2014, 80, 7512–7520. [Google Scholar] [CrossRef] [PubMed] [Green Version]
- Yuan, J.; Raza, W.; Shen, Q.; Huang, Q. Antifungal activity of Bacillus amyloliquefaciens NJN-6 volatile compounds against Fusarium oxysporum f. sp. cubense. Appl. Environ. Microbiol. 2012, 78, 5942–5944. [Google Scholar] [CrossRef] [Green Version]
- Mo, E.K.; Sung, C.K. Phenylethyl alcohol (PEA) application slows fungal growth and maintains aroma in strawberry. Postharvest Biol. Technol. 2007, 45, 234–239. [Google Scholar] [CrossRef]
- Johannes, E.; Litaay, M. The bioactivity of hexadecanoic acid compound isolated from hydroid Aglaophenia cupressina Lamoureoux as antibacterial agent against Salmonella typhi. Int. J. Biol. Med. Res. 2016, 7, 5469–5472. [Google Scholar]
- Al-Marzoqi, A.H.; Hameed, I.H.; Idan, S.A. Analysis of bioactive chemical components of two medicinal plants (Coriandrum sativum and Melia azedarach) leaves using gas chromatography-mass spectrometry (GC-MS). Afr. J. Biotechnol. 2015, 14, 2812–2830. [Google Scholar]
- Jeyadevi, R.; Sivasudha, T.; Ilavarasi, A.; Thajuddin, N. Chemical constituents and antimicrobial activity of Indian green leafy vegetable Cardiospermum halicacabum. Indian J. Microbiol. 2013, 53, 208–213. [Google Scholar] [CrossRef] [PubMed] [Green Version]
- Al-Dhabi, N.A.; Esmail, G.A.; Duraipandiyan, V.; Arasu, M.V.; Salem-Bekhit, M.M. Isolation, identification and screening of antimicrobial thermophilic Streptomyces sp. Al-Dhabi-1 isolated from Tharban hot spring, Saudi Arabia. Extremophiles 2016, 20, 79–90. [Google Scholar] [CrossRef] [PubMed]

| No | Retention Index | Compound | Exact Mass | Formula | Q a (%) | Relative Content(%) b |
|---|---|---|---|---|---|---|
| 1 | 6.387 | 2-Butenoic acid, 3-methyl- | 100.05 | C5H8O2 | 97 | 0.21 |
| 2 | 7.125 | Phenol | 94.04 | C6H6O | 91 | 0.43 |
| 3 | 9.185 | Phenylethyl Alcohol | 122.07 | C8H10O | 87 | 0.15 |
| 4 | 10.455 | Dodecane | 170.20 | C12H26 | 97 | 0.14 |
| 5 | 10.873 | Benzofuran, 2,3-dihydro- | 120.06 | C8H8O | 90 | 0.2 |
| 6 | 11.514 | Benzeneacetic acid | 136.05 | C8H8O2 | 94 | 0.53 |
| 7 | 15.388 | Tetradecane | 198.24 | C14H30 | 98 | 1.15 |
| 8 | 20.400 | Hexadecane | 226.27 | C16H34 | 98 | 0.49 |
| 9 | 22.689 | Z-11-Tetradecenoic acid | 226.19 | C14H26O2 | 91 | 0.21 |
| 10 | 23.645 25.676 25.756 | Pyrrolo[1,2-a]pyrazine-1,4-dione, hexahydro-3-(phenylmethyl)- | 244.12 | C14H16N2O2 | 94 95 99 | 2.80 6.60 3.67 |
| 11 | 24.646 | 1,2-Benzenedicarboxylic acid, bis (2-methylpropyl) ester | 278.15 | C16H22O4 | 91 | 3.62 |
| 12 | 26.071 | n-Hexadecanoic acid | 256.24 | C16H32O2 | 98 | 0.63 |
| 13 | 28.617 | Octadecanoic acid | 284.27 | C18H36O2 | 98 | 0.33 |
| Culture Medium Type | Inhibition Rate (%) | |||
|---|---|---|---|---|
| Culture Time (h) | ||||
| 24 | 48 | 72 | 96 | |
| NB | 93.98 ± 1.34 a | 95.39 ± 1.31 ab | 94.02 ± 0.94 a | 91.38 ± 0.91 c a |
| Landy | 95.61 ± 0.85 a | 94.62 ± 0.48 ab | 98.32 ± 0.33 a | 96.57 ± 0.30 ab |
| TSA | 6.00 ± 1.53 c | 2.25 ± 1.68 d | 5.22 ± 0.94 d | 4.26 ± 0.96 e |
| 10% TSA | 38.86 ± 7.13 b | 66.70 ± 3.32 c | 36.32 ± 5.88 c | 48.09 ± 3.35 d |
| R2A | 38.92 ± 6.35 b | 90.09 ± 1.24 b | 87.16 ± 1.08 a | 92.57 ± 2.53 bc |
| MT | 94.92 ± 1.21 a | 93.74 ± 0.37 ab | 76.15 ± 4.94 b | 87.66 ± 0.84 c |
| Prochloraz (Positive Control) | 98.34 ± 0.55 a | 98.34 ± 0.55 a | 98.34 ± 0.55 a | 98.34 ± 0.55 a |
| Metabolite | Retention Index | Mass Peak, m/z | Characteristic Fragment Ions | MW a | Assignment | |
|---|---|---|---|---|---|---|
| (min) | [M+H]+ | [M+Na]+ | ||||
| Bacilysin | 7.652 | - | 293.71 | - | 270.2 | Bacilysin |
| Bacillaene | 17.567 | 581.78 | - | - | 580.4 | Bacillaene |
| Fengycin | 52.680 | 1449.95 | - | 1080, 966, 896 | 1448.8 | C15 fengycinA |
| 50.638–51.103 | 1463.97 | - | 1080, 966, 896 | 1462.8 | C16 fengycinA | |
| 51.257 | 1477.95 | - | 1094, 980, 896 | 1477.8 | C16 fengycinC | |
| 51.407 | 1491.98 | - | 1108, 994, 896 | 1491.8 | C16fengycinB | |
| 52.377 | 1505.99 | - | 1108, 994, 896 | 1504.8 | C17 fengycinB | |
| Surfactin | 60.078–60.490 | - | 1030.58 | 707, 594, 481 | 1007.7 | C13 surfactinA |
| 60.933–62.042 | - | 1044.66 | 707, 594, 481 | 1021.7 | C14 surfactinA | |
| 61.503–62.200 | - | 1058.66 | 707, 594, 481 | 1035.7 | C15 surfactinA | |
| 61.978–62.453 | - | 1072.67 | 707, 594, 481 | 1049.7 | C16 surfactinA | |
| 63.087 | - | 1086.71 | 707, 594, 481 | 1063.7 | C17 surfactinA | |
Publisher’s Note: MDPI stays neutral with regard to jurisdictional claims in published maps and institutional affiliations. |
© 2022 by the authors. Licensee MDPI, Basel, Switzerland. This article is an open access article distributed under the terms and conditions of the Creative Commons Attribution (CC BY) license (https://creativecommons.org/licenses/by/4.0/).
Share and Cite
Li, Y.; Xia, M.; He, P.; Yang, Q.; Wu, Y.; He, P.; Ahmed, A.; Li, X.; Wang, Y.; Munir, S.; et al. Developing Penicillium digitatum Management Strategies on Post-Harvest Citrus Fruits with Metabolic Components and Colonization of Bacillus subtilis L1-21. J. Fungi 2022, 8, 80. https://doi.org/10.3390/jof8010080
Li Y, Xia M, He P, Yang Q, Wu Y, He P, Ahmed A, Li X, Wang Y, Munir S, et al. Developing Penicillium digitatum Management Strategies on Post-Harvest Citrus Fruits with Metabolic Components and Colonization of Bacillus subtilis L1-21. Journal of Fungi. 2022; 8(1):80. https://doi.org/10.3390/jof8010080
Chicago/Turabian StyleLi, Yongmei, Mengyuan Xia, Pengbo He, Qiaoming Yang, Yixin Wu, Pengfei He, Ayesha Ahmed, Xiangsong Li, Yuehu Wang, Shahzad Munir, and et al. 2022. "Developing Penicillium digitatum Management Strategies on Post-Harvest Citrus Fruits with Metabolic Components and Colonization of Bacillus subtilis L1-21" Journal of Fungi 8, no. 1: 80. https://doi.org/10.3390/jof8010080
APA StyleLi, Y., Xia, M., He, P., Yang, Q., Wu, Y., He, P., Ahmed, A., Li, X., Wang, Y., Munir, S., & He, Y. (2022). Developing Penicillium digitatum Management Strategies on Post-Harvest Citrus Fruits with Metabolic Components and Colonization of Bacillus subtilis L1-21. Journal of Fungi, 8(1), 80. https://doi.org/10.3390/jof8010080

